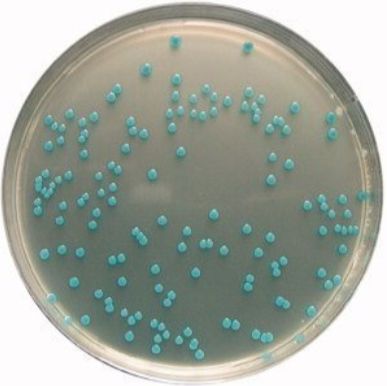
产品封面图

万千商家帮你免费找货
0 人在求购买到急需产品
- 详细信息
- 文献和实验
- 技术资料
- 库存:
72
- 英文名:
Agarivorans albus
- 保质期:
3年
- 供应商:
优利科(上海)生命科学有限公司
- 保存条件:
2-8℃
- 规格:
冻干粉
| 中文名称:白色噬琼胶菌 |
| 拉丁名称:Agarivorans albus |
| 原产国:日本 |
| 模式菌株: 是 |
| 生物安全级别: 一级 |
| 其它保藏中心编号:NBRC 102603=IAM 14998=LMG 21761=KCTC 22256 |
| 培养温度:25℃ |
| 培养时间:24-48h |
| 需氧类型:好氧 |
| 分离基物:帽贝 |
| 采集地:日本 |
| 保存方法: 冷冻干燥管保藏 |

白色噬琼胶菌菌种冻存方法:
菌种保藏是指保持微生物菌株的活力和遗传性状的技术。微生物在使用和传代过程中容易发生污染、变异甚至死亡,因而常常造成菌种的衰退。菌种保藏的目的就是使菌株存活、不丢失、不污染杂菌、不发生或少发生变异,保持菌种原有的活性和各种特征。菌种保藏的基本原理是使微生物的生命活动处于半永久性的休眠状态,也就是将微生物的新陈代谢作用限制在最低范围内。
需氧培养:
大多数的细菌、霉菌、放线菌培养法均为需氧培养。
培养基接种微生物后放于35 ℃~37 ℃或25℃恒温培养箱(或水浴箱)中,培养18 h-24h或3d-5d,大多数菌能看到明显的菌落,可以进行计数及鉴定。需氧培养法按培养基的状态来分,可分为三类。
固体培养法是指将微生物接种在固体培养基上生长繁殖的方法,固体培养基包括琼脂平板和琼脂斜面。琼脂平板用于菌落计数和分离菌落和菌落形态观察,琼脂斜面用于保藏。
液体培养法是利用液体培养基对微生物进行培养的方法,用于菌种的选育及生化试验和发酵试验等。
利用半固体培养基进行培养的方法,半固体培养基含有一定的琼脂(0.02%-0.3% ),使培养基有一定的黏度,但没有完全固化。培养时,盛半固体培养基的试管放置于试管架上,然后置于培养箱中进行培养。一般用于生化试验,可用于判别微生物的运动性。
白色噬琼胶菌注意事项:
1、请务必了解培养微生物需要注意的安全事项,默认由微生物专业技术人员操作;
2、建议严格按照 培养说明来操作,认真阅读说明,尤其是要点提示部分,并记录好菌种编号和菌种制作日期(批号);
3、使用前,认真阅读并理解随货的“菌种培养说明”和“开管说明”如有任何疑问,请于操作前咨询我司。
4、如若有菌种复苏不活或污染等情况,请在收到菌种后1个月内联系我司,逾期将不予受理。

白色噬琼胶菌相关产品:
| 大肠埃希氏菌 | Escherichia coli | 冻干粉;斜面;菌液;平板 | |
| 枯草芽孢杆菌 | Bacillus subtilis | 冻干粉;斜面;菌液;平板 | |
| 摩加夫芽胞杆菌 | Bacillus mojavensis | 冻干粉;斜面;菌液;平板 | |
| 丁酸梭菌 | Clostridium butyricum | 冻干粉;菌液 | |
| 谷氨酸棒杆菌 | Corynebacterium glutamicum | 冻干粉;斜面;菌液;平板 | |
| 蕈状芽孢杆菌 | Bacillus mycoides | 冻干粉;斜面;菌液;平板 | |
| 植物乳杆菌植物亚种 | Lactobacillus plantarum subsp. plantarum | 冻干粉;菌液;平板 | |
| 巨大芽孢杆菌 | Bacillus megaterium | 冻干粉;斜面;菌液;平板 | |
| 鼠李糖乳杆菌 | Lactobacillus rhamnosus | 冻干粉;菌液;平板 | |
| 长双歧杆菌 | Bifidobacterium longum | 冻干粉;菌液;平板 | |
| 枯草芽孢杆菌 | Bacillus subtilis | 冻干粉;斜面;菌液;平板 | |
| 嗜酸乳杆菌 | Lactobacillus acidophilus | 冻干粉;菌液;平板 | |
| 植物乳杆菌 | Lactobacillus plantarum | 冻干粉;菌液;平板 | |
| 嗜酸乳杆菌 | Lactobacillus acidophilus | 冻干粉;菌液;平板 | |
| 动物双歧杆菌 | Bifidobacterium animalis | 冻干粉;菌液;平板 | |
| 无色小杆菌属 | Achromobacter sp. | 冻干粉;斜面;菌液;平板 | |
| 阴沟肠杆菌 | Enterobacter cloacae | 冻干粉;斜面;菌液;平板 | |
| 多粘类芽孢杆菌 | Paenibacillus polymyxa | 冻干粉;斜面;菌液;平板 | |
| 嗜水气单胞菌 | Aeromonas hydrophila | 冻干粉;斜面;菌液;平板 |
风险提示:丁香通仅作为第三方平台,为商家信息发布提供平台空间。用户咨询产品时请注意保护个人信息及财产安全,合理判断,谨慎选购商品,商家和用户对交易行为负责。对于医疗器械类产品,请先查证核实企业经营资质和医疗器械产品注册证情况。
文献和实验菌落杂交法 colony hybridization method
以质粒为载体进行DNA克隆繁殖所用的方法,即从多数寄主菌的菌落中,将含特定的碱基排列顺序的 DNA,通过与其碱基排列顺序互补的 RNA或 DNA杂交而进行检出和选择的方法。一般是使在琼胶培养基上形成含有质粒的菌落后,在其上面压附一层硝酸纤维素薄膜,将菌落移于薄膜上。用碱处理同时引起溶菌和 DNA变性后,在薄膜上各个群落的位置上分别将变性的 DNA固定起来,然后与用放射性同位素标记的特定的 RNA或 DNA片断杂交,再用放射自显影法来鉴别含有所希望的 DNA排列顺序的寄主菌的菌落,最后
杯碟法(琼脂扩散法)cup method,agar diffusion method
又称圆筒平板法( cylinder plate method)。用于测定抗生素效价的生物学定量方法之一。标准的方法是以 20毫升的琼胶培养基放入陪替氏培养皿内做成平面,上面加上预先培养的试验标准菌种,例如掺入了葡萄球菌的琼胶 4毫升,而使之凝固,上面再放上一个外径 8毫米的不锈钢圆筒,筒内倒满青霉素稀释液之后,在 35— 37℃培养 12— 16小时。由于圆筒周围产生浓度梯度,葡萄球菌的繁殖被阻止于有效浓度范围之内而形成圆形的透明带。其直径 d与青霉素浓度 c之间的关系如下式
相关专题 多姿多彩的琼脂 又称圆筒平板法(cylinder plate method)。用于测定抗生素效价的生物学定量方法之一。标准的方法是以20毫升的琼胶培养基放入陪替氏培养皿内做成平面,上面加上预先培养的试验标准菌种,例如掺入了葡萄球菌的琼胶4毫升,而使之凝固,上面再放上一个外径8毫米的不锈钢圆筒,筒内倒满青霉素稀释液之后,在35—37℃培养12—16小时。由于圆筒周围产生浓度梯度,葡萄球菌的繁殖被阻止于有效浓度范围之内而形成圆形